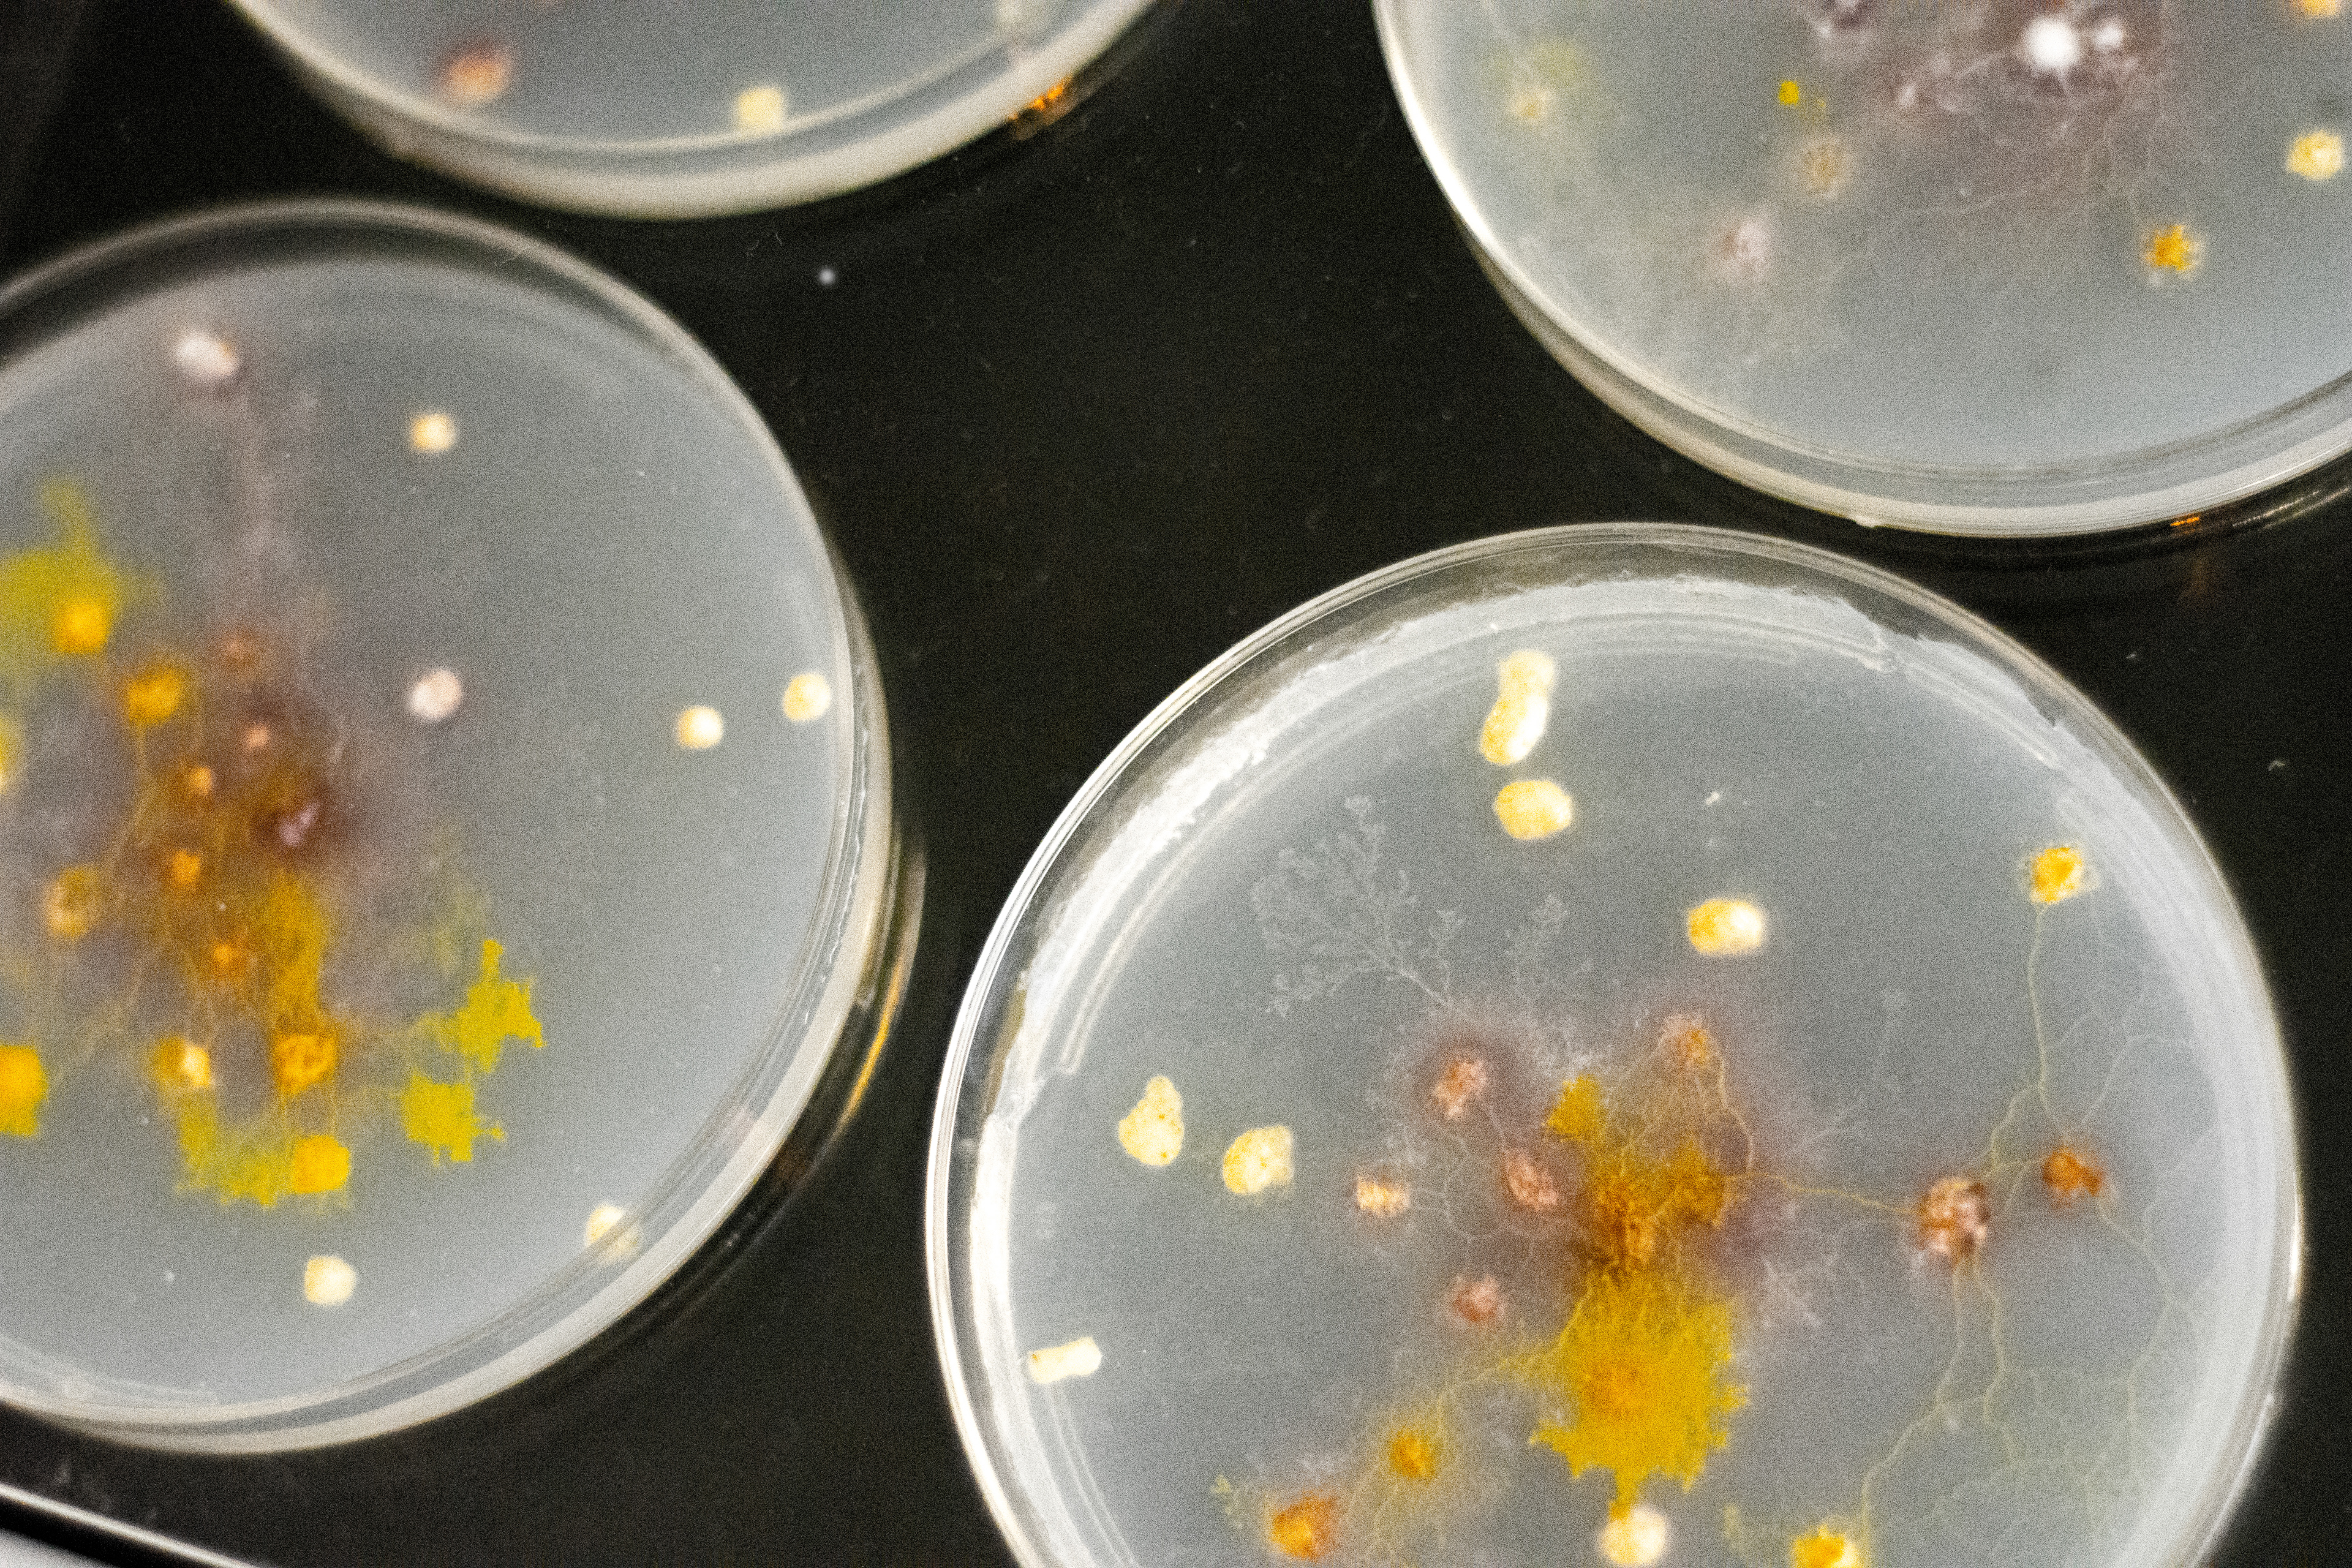

RESEARCH QUESTIONS
What if invisible electromagnetic signals could control the growth of slime molds?
What if the network existed as a consequence of decoding messages coming from outer space?
How would the signal affect the growth of this organism?
A lot of important and fascinating data around us today is being created, transferred, and synthesized for us without us noticing. What we perceive is merely a peek into this data-dense world.

CONCEPT
Blips and Blobs offers the possibility to visualize different patterns of slime growth by decoding signals captured from NOAA satellites.
Those signals will provide different data points on each connection to generate unique multicellular structures. The project aims to highlight the vast range of data and bring to light the non-perceivable nature of data around us by combining satellite data (large-scale/human-made) and slime mold growing process (small-scale/natural) into one system.

FROM SATELLITE TO PETRI DISH
The system is compounded by a 137 MHz custom-made antenna connected to an SDR to capture the signal and record it to be processed. The message is then decoded using an algorithm designed to transform each signal into G-code coordinates that will control a hacked 3d-printer. The bio-printer will provide Food to the slime to generate different growth patterns.

V-DIPOLE ANTENNA + SDR (SOFTWARE DEFINED RADIO)
137 Mhz Antenna To Record Noaa Satellites Fm Signal That Encode An Image. The Recording Format Is A 20800 Hz Sample .wav.

DIY 137 MHz antenna + RTL SDR

Cubic SDR to record satellite signals
decoding sound file using javascript
The sound file recorded using CubicSDR is processed using the FFT algorithm. Each recording translates into distinct patterns whereby each represents a blip sent from the satellite.

Javascript algorithm to convert a satellite recording (audio file) into coordinates for the 3D printing


Algorithm's coordinates fitting petri dish

Petri dish coordinates to G-code for 3D printer
bioprinter (hacked 3d printer + hydraulic pump system)
The 3d printer is hacked and turned into a bioprinter in order to pump oat paste as food for the slime molds. A python script is used to manage the complex pipeline line where the G-Code, the Arduino and the hydraulic pump work together simultaneously through serial communication to visualize the data.

Hacked 3d printed to pump fluid (oats paste) instead of plastic --> Modified from https://www.instructables.com/id/Low-Cost-Bioprinter/

Custom-made pump using linear actuator and Arduino and a custom Python script.

Manual control for the pump

Oats printing system: hacked 3d printer + custom-made fluids pump
slime molds
Slime molds are placed at the center of each petri dish where they grow towards the oats forming organic multicelluar network structure.

Petri dishes display detail
Physarum polycephalum (slime mold) exists as a eukaryotic organism than can live as a single cell or aggregated to form multicellular reproductive structures. The being consists of networks of protoplasmic veins, and many nuclei. It is during this stage that the organism searches for food. The plasmodium surrounds its food and secretes enzymes to digest it. This process is the secret behind the beauty of all those vibrant yellow nodes that keep expanding through time // source wikipedia

Microscope detail on slime growth
NOAA SATELLITES POSTERS

NOAA 15 recordings decoded images

NOAA 18 recordings decoded images

NOAA 19 recordings decoded images
Brooklyn research hosted a presentation for all research projects that happened over the summer. (August 2019).